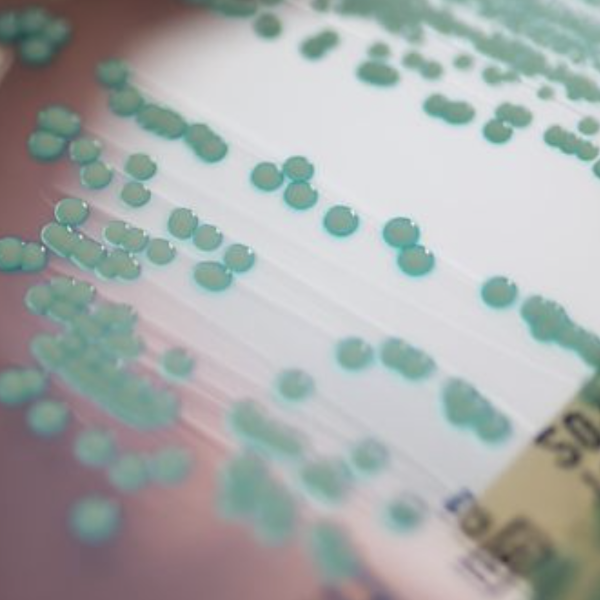

По одной из оценок, в 2019 году более 1,2 миллиона человек во всем мире умерли непосредственно от инфекции, вызванной устойчивым к антибиотикам патогеном. Почти в пяти миллионах смертей такая инфекция была хотя бы частично причиной смерти, сообщает международная группа экспертов в специализированном журнале «The Lancet». Устойчивость к антибиотикам является одной из наиболее распространённых причин смерти во всём мире.
Исследователи изучили 204 страны и региона, 23 патогенных бактерии и 88 комбинаций бактерий и антибиотиков.
Согласно исследованию, 4,95 миллиона смертей были связаны с бактериальной инфекцией, устойчивой к антибиотикам, даже если непосредственная причина смерти, возможно, была другой. 1,27 миллиона человек умерли непосредственно от инфекции резистентной бактерией, поэтому без резистентности этих смертей можно было избежать. Для сравнения: по оценкам, в 2020 году от ВИЧ/СПИДа умерло 680 000 человек, а от малярии — 627 000 человек.
Проблемы с резистентностью особенно распространены при инфекциях нижних дыхательных путей, таких как пневмония. Только они стали причиной 400 000 смертей. Особенно большое количество людей умерло в результате заражения крови и аппендицита, потому что инфекцию нельзя было контролировать антибиотиками из-за устойчивых возбудителей.
Микробы, наиболее часто вызывающие проблемы с резистентностью, включают Escherichia coli, Staphylococcus aureus, Klebsiella pneumoniae и Streptococcus pneumoniae. Микроб MRSA — метициллин-резистентный золотистый стафилококк — стал причиной 100 000 смертей.
Согласно исследованию, больше всего пострадали страны в западной части Африки к югу от Сахары. На каждые 100 000 человек приходится почти 24 случая смерти, которые можно напрямую отнести к заражению устойчивым патогеном. В богатых странах этот показатель составлял 13 смертей на 100 000 человек. Наибольшему риску подвержены дети в возрасте до пяти лет.
Необходимо сократить ненадлежащее использование антибиотиков, например, при вирусных инфекциях, не поддающихся лечению антибиотиками. Необходимо разработать и вывести на рынок новые антибиотики. Исследователи ссылаются на ограниченную доступность данных в некоторых частях мира и различные источники данных как на недостатки своего исследования, которые могут привести к искажениям.

.png)











